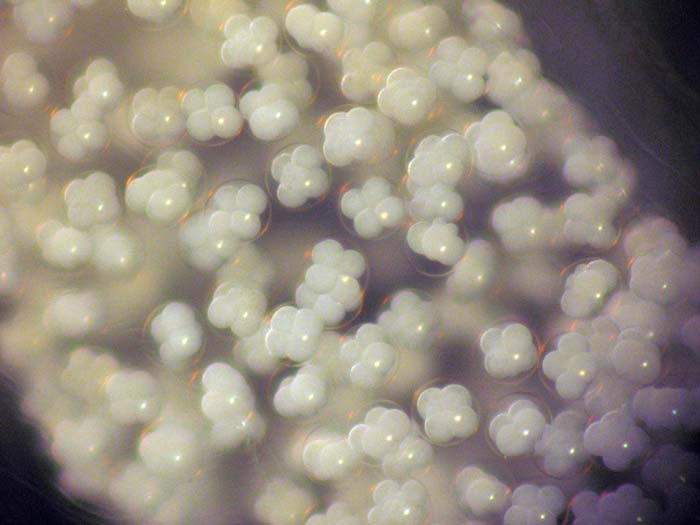

| Nudibranchs - Sunshine Coast etc. / dav5717 All photos Copyright ©2003-2026 Gary Cobb and contributing photographers 12/07/09 Gary Cobb 0416 048 100 gary@nudibranch.com.au |
|
![]() |
| Cerberilla asamusiensis Baba, 1940 | |
| Location: Bulwer, Moreton Island, Queensland Australia Size: 23 mm Depth: 4 m Temperature: 19 C |
ORDER: NUDIBRANCHIA white purple |
| New Record for Australia | |
|
Photographs by Gary Cobb - Copyright 2003-2026 |
|

This egg mass is about 2 hours old!